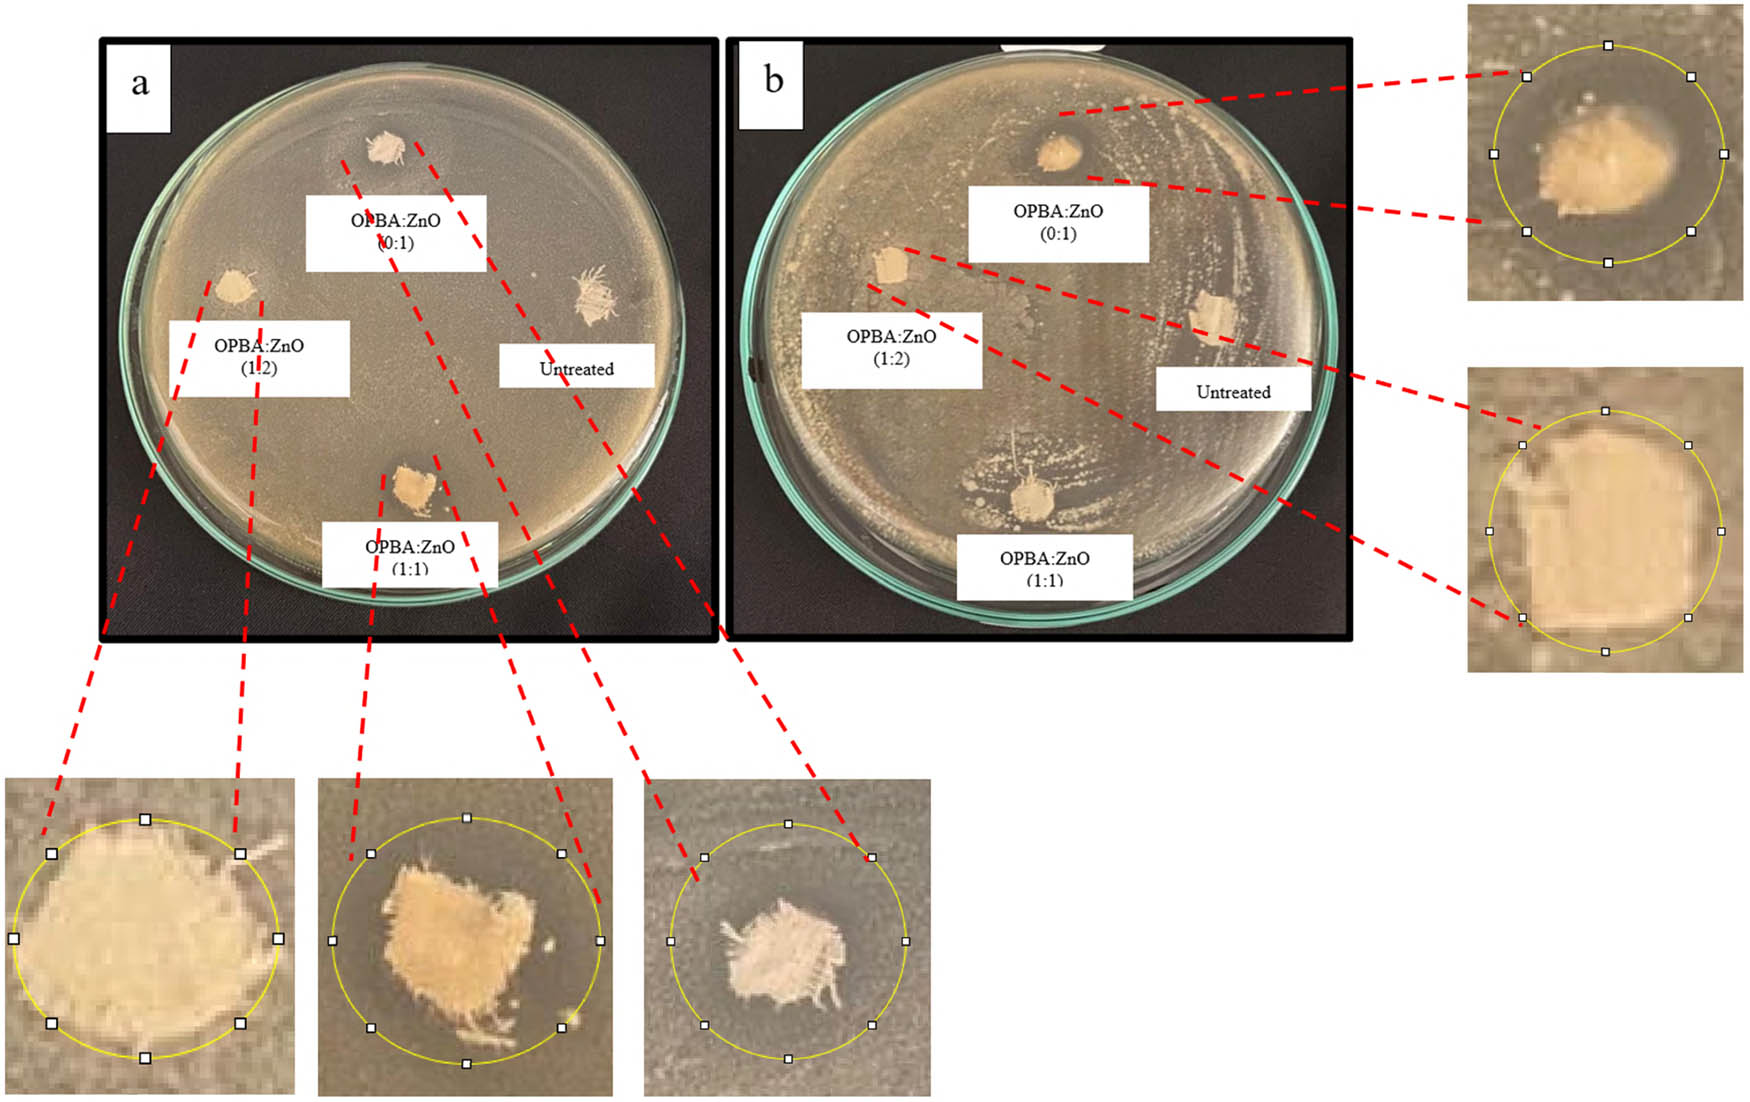

Optimization of oil palm boiler ash waste and zinc oxide as antibacterial fabric coating
-
Bunga Fisikanta Bukit
, Ratnawulan Ratnawulan
Abstract
This study investigated the development of antibacterial fabrics coated with oil palm boiler ash (OPBA) and zinc oxide (ZnO). OPBA was processed via ball milling and co-precipitation to control the nanoparticle size and optimize silica content. The resulting OPBA was combined with ZnO to form a hybrid nanocomposite. The cotton fabric was coated with this nanocomposite using the dip-pad-dry-cure method. The morphology, thermal properties, crystal structure, and antibacterial activities were evaluated. Scanning electron microscopyenergy-dispersive X-ray spectroscopy confirmed the presence of the nanocomposite and its constituent elements on the fabric surface. Differential scanning calorimetry showed an increase in the melting temperature (T m) of the coated fabrics, although this later decreased with increasing ZnO concentration. X-ray diffraction analysis revealed a reduction in the intensity of the characteristic cellulose peaks, indicating a change in the cellulose structure upon coating with OPBA and ZnO. Antibacterial tests showed that the nanocomposite coating inhibited the growth of Staphylococcus aureus bacteria on OPBA:ZnO-coated fabrics at ratios (1:1), (1:2), and (0:1), showing inhibition zones of 3.9, 0.6, and 0.9 mm, respectively. Meanwhile, Escherichia coli-coated fabrics with OPBA:ZnO at ratios (1:1), (1:2), and (0:1) showed inhibition zones of 0, 1.1, and 2 mm, respectively. Furthermore, untreated cotton fabrics showed an inhibition zone of 0. These results demonstrate the potential of this hybrid nanocomposite coating for producing antibacterial textiles suitable for healthcare applications.
Graphical abstract

1 Introduction
Organic–inorganic nanocomposites have been extensively developed in the field of materials science. Hybrid nanocomposites offer the unique advantage of producing materials with superior properties. Previous studies have demonstrated the potential of cotton fabrics treated with hybrid nanocomposites for various applications, including medical, biosensors, and electromagnetic shielding [1,2].
Zinc oxide (ZnO) has found widespread application in diverse fields, including the textile and agricultural industries. Since its inception, ZnO has consistently proven to be a valuable material for the scientific community [3]. Coating cotton textiles with ZnO nanoparticles (NPs) has shown significant potential for enhancing their biological activity, making them suitable for applications such as sports clothing, medical fabrics, and mattresses [4]. ZnO NPs are among various inorganic compounds known to impart antibacterial properties to textiles. Cotton fabrics with antibacterial activity were successfully prepared using zinc oxide/silicon dioxide nanocomposites. In these studies, tetraethyl orthosilicate (TEOS) was used as a precursor to prepare the sol solution for dip coating [5,6].
Silica and its composites have gained significant attention in fabric care because of their high surface area and ease of processing on fabric fibers. Furthermore, SiO2 exhibits high thermal stability and excellent mechanical strength and can enhance the photocatalytic properties when interacting with other semiconductors. However, the production of Si NPs from traditional precursors is expensive. Therefore, there is an increasing need for inexpensive sources of silica NPs. Low-cost silica can be obtained by extracting plantation waste such as oil palm boiler ash (OPBA). Previous research has shown that the silica content extracted from OPBA can range from 50 to 69% depending on the extraction method. Silica from OPBA can be extracted using various methods, including calcination, ball milling, coprecipitation, and the addition of surfactants [7,8,9,10]. In addition to silica, OPBA contains small amounts of calcium (Ca), iron (Fe), magnesium (Mg), and aluminum (Al), which can strengthen nanocomposites, act as connectors in coatings, change the shape of the ZnO particles, and help them adhere to textile fibers. Conventional silica sources such as TEOS are expensive, synthetic, and require significant processing energy. OPBA, on the other hand, is a readily accessible and inexpensive waste product, transforming a disposal challenge into a valuable resource. Its utilization promotes the principles of a circular economy and waste valorization, thereby reducing environmental impact.
In another study, a nanohybrid coating was successfully applied to cotton fabric using an in situ polymerization method in a miniemulsion. The resulting cotton fabric exhibited superior ultraviolet (UV) protection and wash-fastness properties, with a UPF value exceeding 50, even after 50 home washes [11].
ZnO photocatalysts supported on fly ash materials have been shown to exhibit bifunctional properties, combining adsorption capabilities with photocatalytic activity [12]. The combination of SiO2 and ZnO can further enhance the photocatalytic performance and surface adsorption ability, and increase the number of surface hydroxyl groups. Silica-supported ZnO is a promising choice for various applications owing to its excellent thermal and mechanical properties, biocompatibility, and antibacterial properties on diverse substrates, including textiles [13,14].
This study aims to develop an antibacterial cotton fabric for healthcare applications using readily available and economical materials. Extraction of silica from agricultural waste for antibacterial applications has also been investigated. This study focused on coating a cotton fabric with a hybrid nanocomposite derived from OPBA and ZnO to enhance its multifunctional properties, particularly its antibacterial activity. To optimize the silica content and obtain nanoscale OPBA particles, raw OPBA was processed using a combination of ball milling and coprecipitation. The resulting OPBA was combined with ZnO to create a hybrid nanocomposite. This nanocomposite was applied to cotton fabrics using the dip-pad–dry-cure method. This method offers advantages in terms of cost-effectiveness owing to minimal chemical use, simplicity of the process, and near-complete chemical utilization, thus minimizing waste and environmental impact [15]. It also requires less time and can be applied to various types of cellulose fibers. However, optimization of curing time, temperature, and binder concentration is crucial for this process. Finally, the coated cotton fabrics were characterized, and their antibacterial properties were evaluated.
2 Materials and methods
2.1 Materials
OPBA was obtained from PT. Dhajaja Putra Indonesia (North Sumatra, Indonesia). ZnO (density: 5.606 g·cm−3), NH4OH, maleic acid, and sodium hypophosphite were purchased from Sigma Aldrich. Cotton fabrics, 5 M HCl, NaOH, acetic acid, and aqueous solutions were obtained from Medan (Indonesia).
2.2 Methods
2.2.1 Preparation of the hybrid nanocomposite
The raw OPBA was calcined at a temperature of 800°C for 5 h and subsequently dry-milled in a Planetary Ball Mill at 250 rpm for 10 h using a 157 mm sun wheel. Then, the milled OPBA was mixed with 5 M HCl at a 1:4 ratio at 70°C, with pH 0 for 4 h using a magnetic stirrer at a speed of 400 rpm. Then, it was mixed with NH4OH in a ratio of 1:4 at a temperature of 70°C for 4 h using a magnetic stirrer at a speed of 400 rpm. After adding NH4OH, the pH was 14. Finally, the OPBA was washed with distilled water until a neutral pH 7 was achieved, and dried at 100°C for 4 h.
To prepare the nanocomposites, OPBA and ZnO were mixed in 1% acetic acid (60 mL) using a magnetic stirrer for 1 h at 400 rpm. Subsequently, 50 mL of 0.1 M NaOH was added, and the mixture was stirred for 1 h at 400 rpm. Finally, the mixture was washed with distilled water until a neutral pH was achieved. The composition ratios of the nanocomposites are presented in Table 1.
Composition ratios of the nanocomposite
Sample name | OPBA (g) | ZnO (g) |
---|---|---|
Untreated cotton fabric | 0 | 0 |
Coating cotton fabric OPBA:ZnO (1:1) | 10 | 10 |
Coating cotton fabric OPBA:ZnO (1:2) | 10 | 20 |
Coating cotton fabric OPBA:ZnO (0:1) | 0 | 10 |
2.2.2 Preparation of the hybrid coating on cotton fabric
A hybrid coating was applied to cotton fabric using the dip-pad–dry-cure method. The composite prepared in the previous step was mixed with distilled water using a magnetic stirrer for 15 min at 400 rpm. Maleic acid and sodium hypophosphite were dissolved in distilled water using a magnetic stirrer for 1 h at 400 rpm. The nanocomposite dispersion was then mixed with the maleic acid solution for 1 h at 400 rpm.
Commercial cotton fabric was washed and dried to minimize contamination, and then cut into 8 cm × 4 cm pieces. Each fabric piece was immersed in the nanocomposite mixture for 1 h under continuous stirring. After impregnation, the samples were UV-cured for 1 h using a UVC lamp (wavelength range, 180–280 nm; lamp length, 30 cm). Subsequently, the fabrics were dried under sunlight at an ambient temperature of approximately 37.5°C for 4 h.
To estimate the amount of coating deposited on the cotton fabric, the weight of each sample was measured before and after coating. The uncoated fabric weighed 0.725 g. After coating, the weights were 0.926 g for OPBA:ZnO (1:1), 0.906 g for OPBA:ZnO (1:2), and 1.278 g for OPBA:ZnO (0:1).
2.2.3 Fourier transform infrared (FTIR) analysis
FTIR spectroscopy was utilized to examine the chemical interactions in the nanocomposites on cotton fabric, employing a Shimadzu IR Prestige 21 instrument with a scanning range of 4,000–400 cm−1 and a resolution of 4 cm−1. The fabric sample was sectioned into small pieces, approximately 1 cm2 or smaller, and positioned directly on the ATR crystal. Light pressure was utilized to ensure optimal contact between the sample and the crystal. The pressure is generally adjustable via a screw or lever on an ATR accessory. The spectrum exhibited peaks at distinct wavelengths, each corresponding to specific molecular vibrations within the sample. The spectrum facilitated the identification of functional groups and characteristics of the textile materials. Graphic processing was conducted utilizing OriginLab software.
2.2.4 Fabric morphology analysis
The morphology and dispersion of the hybrid nanocomposite on the fabric substrate were investigated using scanning electron microscopy (SEM; FEI Inspect-S50). Fabric samples are typically non-conductive, meaning that they must be conductive for SEM analysis. This was achieved by coating the samples with a thin Au layer. The fabric was cut to approximately 1 cm × 1 cm to ensure that it was sufficiently small for mounting on the SEM stage. Energy-dispersive spectroscopy (EDS) was used to determine the elemental composition of the fabric. This provided elemental maps and spectra to identify the chemical elements present.
2.2.5 X-ray diffraction (XRD) analysis
XRD analysis was conducted to quantitatively assess the phase proportions and crystallinity using a PANalytical Xpert PRO instrument. A Cu/Kα1 X-ray source (λ = 1.54056 Å) was employed with a scanning range of 10–70° 2θ. Data processing was performed using Origin software, and phase identification was achieved using Match software, utilizing the COD database. The crystallite size was calculated using the Scherrer equation:
where D is the mean size of the ordered (crystalline) domains, K is the constant function of the crystallite shape, λ is the X-ray wavelength, β is the line broadening at half the maximum intensity (FWHM), and θ is the Bragg angle.
2.2.6 Differential scanning calorimetry (DSC) analysis
Thermal properties were investigated using a Perkin Elmer DSC 4000 instrument. Samples were heated from −10 to 350°C. DSC characterization was used to determine the thermal properties of fabrics, such as melting point, glass transition temperature (T g), and crystallization behavior, which can provide valuable insight into fabric composition, processing conditions, and performance. Fabric samples should generally weigh between 5 and 10 mg. The sample was sufficiently small to fit into the sample container (usually a few millimeters in size). Graphic processing was performed using OriginLab software.
2.2.7 Antibacterial activity
Antimicrobial testing was performed against Staphylococcus aureus and Escherichia coli in two steps. First, the work area was sterilized, and bacterial isolates were obtained. Each bacterial isolate was diluted with 10 mL of sterile distilled water and adjusted to a McFarland turbidity of 108 CFU·mL−1. Second, Mueller–Hinton agar (MHA) medium was poured into sterile Petri dishes and allowed to solidify. A sterile cotton swab was dipped into the bacterial suspension and evenly applied to the surface of the MHA. The location of the sample placement was marked on the base of a Petri dish. A circular fabric sample approximately 6 mm in diameter was cut and placed at the marked location. The Petri dishes were incubated at 35°C for 24 h. Antibacterial testing was performed in a biosafety cabinet equipped with a UV lamp with a 254 nm wavelength (UV-C band). Finally, the diameter of the clear zone formed around each fabric sample was measured to assess antibacterial activity.
3 Results and discussion
3.1 FTIR analysis
FTIR spectroscopy was utilized to evaluate the chemical interactions within the fabricated composites, as illustrated in Figure 1. Distinct vibration bands were found at 736.95, 1710.86, 2906.73, 2968.45, and 3429.43 cm⁻1 in cotton samples treated with OPBA and ZnO. The peaks observed are connected to the stretching movements of O–H and C–H bonds, indicating the presence of natural cotton materials such as cellulose, lignin, and hemicellulose [16]. The FTIR spectrum of the untreated cotton fabric (Figure 1a) displayed distinct peaks associated with cellulose, the primary structural component of cotton. An absorption band around 3,429 cm⁻1 was found, indicating that there are stretching movements of O–H bonds related to the hydroxyl groups. The peaks at 2,968 and 2,906 cm⁻1 correspond to symmetric and asymmetric C–H stretching vibrations, respectively, while the peak at 1,710 cm⁻1 is attributed to C═O stretching, likely originating from hemicellulose or pectin residues. A prominent peak at 732 cm⁻1 was identified as indicative of C–H bending vibrations. The assignments align with previously documented FTIR spectra of cellulose-based fibers [17].

FTIR spectra of untreated and coated cotton fabric.
The application of the OPBA–ZnO nanocomposite on the cotton fabric resulted in noticeable spectral alterations. In the OPBA:ZnO (1:1)-coated sample (Figure 1b), the O–H stretching peak at approximately 3,429 cm⁻1 exhibited diminished intensity or broadening. In the OPBA:ZnO (1:2) sample (Figure 1c), new peaks emerged around 1,743 cm⁻1, and a shift was observed at approximately 736 cm⁻1, indicating the presence of additional functional groups. The spectrum of the sample that was only coated with ZnO (Figure 1d) showed a peak at 3,568 cm⁻1, which was caused by water molecules sticking to the ZnO surface. A peak at 1,643 cm⁻1 was observed, likely attributed to C═O stretching from surface-bound CO2 or other organic compounds. A prominent peak at 736 cm⁻1 was attributed to Zn–O stretching vibrations [18]. The characteristic peaks of cellulose were significantly reduced in this sample.
The FTIR results validate the effective functionalization of cotton fabrics using the OPBA–ZnO nanocomposite. The decrease in the strength of the O–H stretching in the OPBA:ZnO (1:1) sample suggests that there may be hydrogen bonding or interactions between the hydroxyl groups in cellulose and the coating materials. The emergence of new absorption bands and peak shifts in the OPBA:ZnO (1:2) sample suggests the introduction of additional chemical groups, likely derived from excess ZnO or OPBA [19]. The detected spectral differences in ZnO-only-coated fabric provide more insight into the coating procedure. The weakening of cellulose signals and the strong peaks associated with ZnO suggest that the ZnO layer covers the cotton fibers in a smooth or partially protective manner. This effect is explained by infrared-reflective qualities of ZnO, which may reduce or obscure infrared absorbance from underlying materials. Prior studies have confirmed the superior UV and infrared blocking properties of ZnO-coated textiles, supporting their use in functional fabric applications [20].
3.2 Fabric morphology analysis
The surface morphology of both untreated and coated cotton fabrics was analyzed using SEM, as illustrated in Figure 2. The untreated cotton fabric (Figure 2a) displayed a characteristic morphology, where the fibers presented a relatively smooth surface, accompanied by natural twists and convolutions [21]. The fiber surfaces were observed to be clean and devoid of notable surface deposits or agglomerates. Coating the fabric with the OPBA–ZnO nanocomposite resulted in notable morphological changes. In the OPBA:ZnO (1:1) sample (Figure 2b), the fiber surfaces became rougher, and there was material connecting each fiber, indicating a network-like pattern. In the OPBA:ZnO (1:2) sample (Figure 2c), there was an increase in surface roughness, accompanied by a greater amount of material observed between the fibers. The coating exhibited a relatively uniform distribution; however, the possibility of localized areas with higher material concentration or agglomeration cannot be excluded [22]. The fabric coated only with ZnO (0:1, Figure 2d) showed a different structure, marked by clumps of NPs that were not evenly spread on the fiber surfaces. A summary of the main findings of SEM is shown in Table 2.

SEM of (a) untreated cotton fabric, (b) coated cotton fabric OPBA:ZnO (1:1), (c) coated cotton fabric OPBA:ZnO (1:2), and (d) coated cotton fabric OPBA:ZnO (0:1).
Summary of key visual SEM findings
Sample | Surface texture | Observed features | Agglomerate size (µm) |
---|---|---|---|
Untreated cotton | Smooth, fibrous | Clean fiber surfaces | None |
Coated OPBA:ZnO (1:1) | Rough, coated | Coating bridges between fibers | ∼1.5 |
Coated OPBA:ZnO (1:2) | Rougher, denser coating | Denser material between fibers, some clumps | ∼2–3 |
Coated ZnO only (0:1) | Agglomerated | Random ZnO clumps on the surface | ∼2–4 |
SEM analysis confirmed the successful deposition of the OPBA–ZnO nanocomposite coating. The increased roughness and interfiber bonding observed in the OPBA:ZnO-coated samples (1:1 and 1:2) indicated that the nanocomposite adhered well to the cotton fibers. The more pronounced surface texture in the 1:2 sample indicated a higher ZnO content, likely due to the higher ZnO content in the formulation. The network-like structure in the 1:1 and 1:2 samples indicated increased interfiber connectivity, which could enhance surface functionalities such as hydrophobicity or photocatalytic activity [17]. In contrast, the ZnO agglomerate without OPBA (0:1 sample) exhibited poor dispersion and reduced coating uniformity. This highlights the crucial role of OPBA in facilitating the even distribution of ZnO NPs and minimizing aggregation [23].
The elemental compositions of untreated and coated cotton fabrics were analyzed using energy-dispersive X-ray spectroscopy (EDX), with the findings presented in Table 3. The untreated cotton fabric predominantly comprises carbon (81.2 wt%) and oxygen (18.8 wt%), aligning with the cellulosic composition of cotton. Following the application of the OPBA–ZnO nanocomposite, supplementary elements were identified in the textiles. In the OPBA:ZnO (1:1) sample, components including Si (0.5 wt%), P (0.4 wt%), Ca (0.1 wt%), and Zn (0.2 wt%) were detected, in addition to increased concentrations of oxygen. The OPBA:ZnO (1:2) sample demonstrated an elevated Zn content (1.3 wt%) along with augmented levels of Si (1.3 wt%), P (1.9 wt%), and additional trace elements such as Na, Mg, and Fe. The ZnO-only coated sample (OPBA:ZnO 0:1) exhibited a significant presence of Zn (7.8 wt%), whereas components related to OPBA – namely Si, Mg, Ca, and Fe – were either nonexistent or present in minimal quantities.
Elemental compositions of the samples from the EDX spectroscopy analysis
Sample | Element (wt%) | ||||||||
---|---|---|---|---|---|---|---|---|---|
C | O | Na | Mg | Si | P | Ca | Fe | Zn | |
Untreated cotton fabric | 81.2 | 18.8 | — | — | — | — | — | — | — |
Coated cotton fabric OPBA:ZnO (1:1) | 66.5 | 32.5 | 0.1 | — | 0.5 | 0.4 | 0.1 | — | 0.2 |
Coated cotton fabric OPBA:ZnO (1:2) | 59.3 | 33.6 | 1.7 | 0.1 | 1.3 | 1.9 | 0.5 | 0.2 | 1.3 |
Coated cotton fabric OPBA:ZnO (0:1) | 70.4 | 21.6 | — | — | 0.3 | — | — | — | 7.8 |
The successful addition of OPBA to the coating is shown by the detection of Si, Mg, Ca, and Fe in the samples that contain OPBA [7,24]. The characteristics of OPBA suggest that the OPBA component was successfully deposited onto the cotton fibers. The presence of Zn confirms the incorporation of ZnO NPs in all coatings that contain ZnO. The higher amount of Zn in the OPBA:ZnO (1:2) sample indicates that there is more ZnO in the coating mix, supporting the idea that the amount of elements deposited changes with the mix used. The differences in elemental concentrations between the 1:1 and 1:2 samples may result from variations in coating uniformity or localized accumulation of OPBA particles. The elevated Zn content in the ZnO-only sample (0:1) and the absence of OPBA-associated elements highlight OPBA’s role as a separate contributor to the composite composition. The detected trace amount of Si in this sample may result from minor contamination during the coating process. The presence of P can be attributed to the use of sodium hypophosphite in the coating [25].
3.3 XRD analysis
XRD analysis was carried out to examine the crystal structures and phase compositions of untreated and coated cotton fabrics. The diffraction patterns are presented in Figure 3, and the derived crystallographic parameters are summarized in Table 4. Untreated cotton fabric (Figure 3a) exhibits characteristic cellulose peaks at 2θ values of 17.31°, 22.47°, and 25.42°, corresponding to the (202), (114), and (117) planes [26]. The calculated crystallite size is 9.98 nm. This is consistent with the typical monoclinic structure of cellulose. OPBA:ZnO (1:1) (Figure 3b) shows new diffraction peaks appearing at 16.27°, 17.65°, 25.66°, and 28.48°, while the cellulose peak intensities are reduced. The calculated crystallite size increases to 25.87 nm, and the crystal system shifts to tetragonal [27]. OPBA:ZnO (1:2) (Figure 3c) shows peaks at 16.59°, 28.65°, and 31.76°, with an even larger crystallite size of 34.26 nm. The crystal system remains tetragonal. OPBA:ZnO (0:1) (Figure 3d) displays multiple sharp peaks at 10.93°, 11.80°, 16.06°, 19.22°, 21.60°, 26.10°, 29.42°, 31.18°, 34.29°, 36.1°, 47.43°, 58.81°, 62.74°, and 68.99°, corresponding to the (100), (002), (101), (012), (110), (013), and (112) planes of hexagonal ZnO, respectively. The crystallite size is 35.86 nm.

Diffraction XRD patterns of untreated and coated cotton fabric.
Parameters resulting from XRD analysis
Sample | Crystal size (nm) | 2θ (°) | Crystal system | d hkl |
---|---|---|---|---|
Untreated cotton fabric | 9.98 | 17.31, 22.47, 25.42 | Monoclinic | 202, 114, 117 |
Coated cotton fabric OPBA:ZnO (1:1) | 25.87 | 16.27, 17.65, 25.66, 28.48 | Tetragonal | 110, 012, 201 |
Coated cotton fabric OPBA:ZnO (1:2) | 34.26 | 16.59, 28.65, 31.76 | Tetragonal | 210, 101, 231 |
Coated cotton fabric OPBA:ZnO (0:1) | 35.86 | 10.93, 11.80, 16.06, 19.22, 21.60, 26.10, 29.42, 31.18, 34.29, 36.1, 47.43, 58.81, 62.74, 68.99 | Hexagonal | 100, 002, 101, 012, 110, 013,112 |
The untreated fabric predominantly consists of cellulose, as indicated by the XRD patterns; however, coating it with OPBA–ZnO composites results in significant structural alterations. The emergence of new crystalline phases, possibly comprising SiO2 from the OPBA and ZnO-based compounds, is suggested by the presence of new peaks in the 1:1 and 1:2 coated fabrics [28]. The reduction in the cellulose peak intensity suggests that the coating has interfered with or obscured the inherent cellulose structure. The coated samples exhibit larger crystallite sizes, suggesting the presence of larger nanocrystalline domains, particularly with increasing ZnO content. ZnO NPs were effectively deposited in the 0:1 (ZnO-only) sample, exhibiting a well-defined hexagonal ZnO structure with high crystallinity [29,30]. The XRD data indicate the influence of material ratios on the quality and structure of the coatings, confirming the incorporation of OPBA and ZnO into the cotton fabrics.
3.4 DSC analysis
DSC analysis was performed to investigate the thermal transitions of untreated and coated cotton fabrics. The DSC thermograms are presented in Figure 4, and the corresponding thermal parameters, including the glass transition temperature (T g) and melting temperature (T m), are summarized in Table 5. The untreated cotton fabric exhibited the lowest T g and T m values among all samples. Upon coating with OPBA, both T g and T m increased, indicating an enhancement in thermal resistance. The OPBA:ZnO (1:1) and (1:2) coated fabrics showed elevated T g values, with the maximum reaching 129.55°C. However, an inverse trend was observed for the melting point with increasing ZnO concentration. The ZnO-only coated fabric (OPBA:ZnO = 0:1) exhibited the lowest melting point of 146.33°C, despite ZnO’s known high thermal stability. Previously reported studies have identified thermal events at 81, 152, 210, 245, 136, 187, and 295°C, corresponding to moisture evaporation and decomposition of hydroxide groups [31].

DSC thermograms of untreated and coated cotton fabric.
Thermal parameters obtained from DSC characterization
Sample | T m1 (oC) | T m2 (oC) | T m3 (oC) | T m4 (oC) | T g | |
---|---|---|---|---|---|---|
Onset | Midpoint | |||||
Untreated cotton fabric | 183.67 | 254.67 | — | — | 80.84 | 78.40 |
Coated cotton fabric OPBA:ZnO (1:1) | 184.67 | 254.67 | — | — | 90.27 | 91.07 |
Coated cotton fabric OPBA:ZnO (1:2) | 108.33 | 134.67 | 204.33 | 255.33 | 119.23 | 112.67 |
Coated cotton fabric OPBA:ZnO (0:1) | 146.33 | 255.57 | — | — | 129.55 | −11.00 |
The increase in T g in all coated fabrics indicates that the polymer chain stiffness and thermal stability have increased, thus improving the heat resistance. The decrease in melting points with increasing ZnO concentration is due to ZnO interference in the OPBA matrix, which potentially disrupts thermal insulation and reduces the crystal order. Even though ZnO has a very high melting point (∼1,975°C) and turns into a gas above 1,200°C, adding it to the nanocomposite coating can change how the matrix behaves without breaking down at the temperatures we tested. The finding suggests that although ZnO increases T g by strengthening the polymer network, it can also function as a plasticizing or dispersing agent that reduces T m [32].
The coating affects the thermal properties of cotton fabric, as indicated by the characterization results. Untreated cotton fabric showed a T m1 of 183.67°C. Coated samples showed varying melting temperatures, with some coatings increasing the T m and others decreasing it. Additionally, the OPBA–ZnO coating exhibited a higher T g value, which suggests that it has enhanced thermal resistance. The presence of silica in OPBA is responsible for the increase in T g, as it restricts the mobility of cellulose chains, thereby enhancing heat resistance. T m is marginally reduced by the sole application of ZnO coating, which is likely the result of changes in the crystal structure or ZnO-induced effects. The OPBA–ZnO nanocomposite enhances the thermal stability of the fabric by altering its thermal behavior, as confirmed by DSC. This is predominantly due to the synergistic effect of silica and ZnO. Supporting evidence from XRD and FTIR analyses strengthens the effect of the coating on the fabric. XRD analysis shows changes in the crystallinity of cellulose, indicating a structural transformation that aligns with the observed thermal behavior. FTIR data support the incorporation of a coating material that can alter the molecular interactions that influence thermal transitions. However, the lack of thermogravimetric analysis (TGA) data is a limitation of this study, preventing precise interpretation of the degradation behavior and thermal stability of the layered system. While DSC provides insights into thermal transitions such as T g and T m, TGA should complement this by quantifying weight loss, decomposition temperature, and residue content, which are crucial for independently confirming the thermal contributions of ZnO and OPBA.
3.5 Antibacterial activity
Antibacterial activities of the untreated and coated cotton fabrics against S. aureus (Gram-positive) and E. coli (Gram-negative) were evaluated using a standard agar diffusion method. Figure 5 shows representative images of the Petri dishes after 24 h of incubation, illustrating the zones of inhibition around the fabric samples. Table 6 summarizes the average diameters of inhibition zones for each sample. The results show that the untreated cotton fabric did not exhibit any noticeable inhibition of S. aureus or E. coli. This result was expected because untreated cotton does not possess inherent antibacterial properties.
Antibacterial activity of untreated and coated cotton fabrics against (a) S. aureus and (b) E. coli. Images show representative Petri dishes after 24 h of incubation. The inhibition zones (indicated by circles) represent areas where bacterial growth was inhibited. The diameter of each inhibition zone was measured in millimeters.
Inhibition zone diameters (mm, mean ± SD, n = 3) of S. aureus and E. coli
Sample | S. aureus (mm) | E. coli (mm) |
---|---|---|
Untreated cotton fabric | 0.0 ± 0.0 | 0.0 ± 0.0 |
Coated cotton fabric OPBA:ZnO (1:1) | 3.9 ± 0.00 | 0.0 ± 0.0 |
Coated cotton fabric OPBA: ZnO (1:2) | 0.6 ± 0.30 | 1.1 ± 0.10 |
Coated cotton fabric OPBA:ZnO (0:1) | 0.9 ± 0.15 | 2 ± 0.17 |
In contrast, cotton fabrics coated with the OPBA–ZnO nanocomposites showed varying degrees of antibacterial activity. For S. aureus (Figure 5a), the OPBA:ZnO (1:1)-coated fabric showed the largest inhibition zone, measuring 3.9 mm in diameter. This indicates the significant antibacterial effect of this coating formulation against Gram-positive bacteria. The OPBA:ZnO (1:2)-coated fabric exhibited a smaller inhibition zone (0.6 mm), suggesting a reduced antibacterial effect compared to the 1:1 ratio. The ZnO-only (0:1)-coated fabric exhibited an inhibition zone of 0.9 mm, demonstrating that ZnO alone contributed to the antibacterial activity. Against E. coli (Figure 5b), the trend in antibacterial activity was somewhat different. The OPBA:ZnO (1:1)-coated fabric, which exhibited the strongest activity against S. aureus, did not inhibit E. coli. The OPBA:ZnO (1:2)-coated fabric exhibited a small inhibition zone (1.1 mm), indicating antibacterial activity against Gram-negative bacteria. The ZnO-only (0:1)-coated fabric showed an inhibition zone of 2 mm against E. coli, demonstrating antibacterial activity, although it was less pronounced than its activity against S. aureus. Furthermore, untreated cotton fabrics showed an inhibition zone of 0. In this study, OPBA-only coated samples were not included. However, previous research has shown that OPBA-coated fabrics have antibacterial activity with an inhibition zone of 6.4 mm [33].
The differences in antibacterial activity between the different coating formulations can be attributed to several factors, including the relative amounts of OPBA and ZnO in the coatings, distribution, and morphology of the nanocomposite on the fabric surface, and specific bacterial species. The stronger activity of the OPBA:ZnO (1:1) coating against S. aureus suggests that this specific ratio may be optimal for inhibiting the growth of Gram-positive bacteria. The lower activity of the OPBA:ZnO (1:2) coating, despite containing more ZnO, suggests that OPBA may play a synergistic role at a 1:1 ratio, possibly by enhancing the interaction between ZnO and the bacterial cell wall. The differences in activity between S. aureus and E. coli could be due to the differences in their cell wall structures and compositions. Gram-positive bacteria, such as S. aureus, have a thicker peptidoglycan layer, while Gram-negative bacteria, such as E. coli, have a more complex cell wall structure, including an outer membrane, which could affect their susceptibility to antibacterial agents.
The enhanced antibacterial efficacy of substrates loaded with metal oxide NPs can be attributed to several mechanisms. These include photocatalytic activity that enables the generation of highly reactive oxygen species (ROS) in the presence of light and water. ROS can effectively attack, damage, and destroy bacterial cells. Furthermore, the interaction between the positively charged cationic sites of the antimicrobial agent and the negatively charged cell wall of the pathogen can disrupt the cell membrane function, inhibit protein activity, and prevent bacterial multiplication [33–35]. Additionally, the enhanced antibacterial activity of the coated fabrics can be attributed to several mechanisms associated with the ZnO NPs. A primary mechanism is the release of Zn2⁺ ions, which are known to be toxic to bacteria. These ions disrupt bacterial cell membranes, interfere with essential metabolic processes, and inhibit bacterial growth [36].
Furthermore, direct contact between ZnO NPs and the bacterial cell wall can contribute to antibacterial activity. NPs can physically damage the bacterial membrane, leading to the leakage of cellular contents and, ultimately, cell death [37]. The size and morphology of the ZnO NPs can influence the extent of both Zn2⁺ release and direct contact, which may explain the observed differences in antibacterial activity between the different coating formulations. The interaction of the ZnO-coated and OPBA-coated surface charges may have positively charged regions that attract and interact with the negatively charged bacterial cell wall, enhancing membrane disruption and antimicrobial efficacy. The synergistic effect of OPBA with silica also contributes to its antibacterial effect. The silica content in OPBA increases the surface area for ZnO dispersion, enhances ROS activity by providing hydroxyl groups, and prevents nanoparticle agglomeration. This results in more effective contact and antibacterial activity.
The structural alterations identified through XRD and FTIR spectroscopy not only validate the presence and interaction of the nanocomposite with cotton fibers but also elucidate the mechanism underlying the augmented antibacterial efficacy through enhanced dispersion, chemical bonding, and the production of antibacterial agents such as Zn2⁺ ions and ROS. Fabrics coated with OPBA:ZnO 1:1 exhibited diminished intensity of cellulose peaks and the emergence of additional peaks linked to ZnO and SiO2 phases. This signifies the successful incorporation of ZnO and OPBA into the fiber matrix. Increased crystallite sizes in coated samples (up to 35.86 nm for ZnO) indicate improved surface exposure, essential for the release of Zn2⁺ ions, which compromise bacterial membranes and promote photocatalytic ROS formation, hence harming bacterial cells. Decreased cellulose crystallinity indicates enhanced coating penetration, facilitating superior interaction with microorganisms. Furthermore, coated fabrics exhibited alterations in the intensity within the O–H, C═O, and Si–O–Si vibrational bands. New peaks related to Zn–O bonds and Si-based functional groups emerged. The cellulose matrix exhibited increased binding of ZnO and OPBA, consequently improving durability and contact efficiency. Si–O groups may facilitate the incorporation of hydroxyl groups onto the surface, thereby enhancing the generation of ROS during light exposure.
To statistically verify the observed differences in antibacterial activity between the untreated and coated cotton fabrics, one-way analysis of variance (ANOVA) was performed. ANOVA results are presented in Table 7.
ANOVA for antibacterial activity
ANOVA | ||||||
---|---|---|---|---|---|---|
Bacterial | Sum of squares | df | Mean square | F | Sig. | |
S. aureus | Between groups | 24.484 | 3 | 8.161 | 17.299 | 0.001 |
Within groups | 3.774 | 8 | 0.472 | |||
Total | 28.258 | 11 | ||||
E. coli | Between groups | 8.303 | 3 | 2.768 | 332.100 | 0 |
Within groups | 0.067 | 8 | 0.008 | |||
Total | 8.369 | 11 |
For S. aureus, ANOVA revealed a statistically significant difference in antibacterial activity between the groups (untreated and coated fabrics) (F = 17.299, df = 3, p = 0.001). The p-value of 0.001 was below the significance level of 0.05, indicating that the observed differences in the inhibition zone diameters were unlikely to be due to chance. This confirmed that the coating treatment had a statistically significant effect on the antibacterial activity against S. aureus. An F-statistic of 17.299 indicated a strong effect size, suggesting that the coating had a substantial impact on the inhibition of S. aureus.
Similarly, for E. coli, the ANOVA test showed a statistically significant difference in antibacterial activity between the groups (F = 332.100, df = 3, p < 0.001). A p-value of less than 0.001 was below the significance level of 0.05, confirming that the observed differences in inhibition zone diameters were highly significant and were not due to random variation. The high F-statistic of 332.100 suggested an extremely strong effect size, indicating that the coating had a very large impact on inhibiting the growth of E. coli.
These ANOVA results provide strong statistical evidence to support the conclusion that the OPBA–ZnO nanocomposite coating and the ZnO-only coating significantly enhanced the antibacterial activity of cotton fabrics against both S. aureus and E. coli. The significant F- and low p-values indicate that the observed differences in the inhibition zone diameters between the untreated and coated fabrics are not due to chance but rather reflect a real effect of antibacterial treatments. Furthermore, the statistical significance of the results strengthened the reliability of the observed trends in antibacterial activity across different coating formulations.
3.6 Role of OPBA in the nanocomposite
OPBA plays several crucial roles in enhancing the properties of coated cotton fabrics and in the nanocomposite system. First, OPBA is a cost-effective and sustainable source of silica. Silica derived from OPBA is believed to be a major contributor to the improved thermal stability of the coated fabrics. The DSC analysis (Figure 4, Table 5) revealed a significant increase in the glass transition temperature (T g) of the coated fabrics compared to that of the untreated cotton. For example, the T g of the fabric coated with OPBA:ZnO (1:2) increased from 80.84 to 119.23°C. This increase suggests that the silica network derived from OPBA enhanced the thermal resistance of the cotton fibers, likely by restricting the segmental motion of the cellulose chains. The porous and reactive nature of OPBA silica improves the dispersion and adhesion of ZnO NPs on the cotton surface. SEM images showed a uniform distribution and less agglomeration when OPBA was added. OPBA contributes to the antibacterial efficacy by increasing the surface area around the ZnO particles and increasing the acidity of the photocatalytic surface, which facilitates the formation of larger hydroxyl radicals. OPBA also contains trace elements (Ca, Fe, Mg, etc.) detected through EDX, which may act as crosslinkers or affect the morphology of the ZnO crystals, which in turn affects the coating behavior.
Furthermore, the silica matrix from the OPBA may have contributed to the improved adhesion of the ZnO NPs to the cotton fibers. SEM images (Figure 2) show a relatively uniform distribution of particles on the coated fabric surface, suggesting good adhesion. Although further investigation, such as XPS or TEM, is needed to definitively confirm the mechanism of adhesion, the presence of silica may facilitate the binding of ZnO to the cellulose fibers through hydrogen bonding.
In addition to silica, OPBA contained other elements, including Al, Fe, Ca, and Mg, which were detected in the coated fabric using EDX analysis (Table 3). Although the precise roles of these elements are not fully understood, their presence may contribute to the overall properties of the coatings. For instance, these elements could potentially act as crosslinkers or binders, further strengthening the interaction between the ZnO NPs and cotton fibers. They may also influence the growth and morphology of the ZnO NPs during the synthesis process, affecting their size and distribution. However, further studies are required to elucidate the specific contributions of these elements. In the antibacterial test, the largest average diameter of the S. aureus bacterial inhibition zone was found for the OPBA:ZnO (1:1) cotton fabric coating, which was 3.9 mm. The effective antibacterial mechanism was attributed to the influence of silica in OPBA on increasing the surface area around the ZnO particles. Silica can also strengthen the acidity of the photocatalyst surface, increasing the participation of hydroxyl groups in photocatalytic activity [38,39].
The utilization of OPBA as a silica source presents distinct environmental and economic advantages; however, it is crucial to evaluate the possibility of leaching ZnO or silica NPs during the use or laundering of the fabric. Extended washing or mechanical abrasion may lead to the partial release of NPs, potentially impacting long-term antibacterial efficacy and raising environmental or health issues. This study found no significant leaching after a standard wash cycle; however, additional testing, including inductively coupled plasma (ICP) analysis or wash resistance testing, is advisable to measure the extent of release. Although washing durability was not evaluated in the present study, previous work demonstrated that the coated cotton fabrics exhibited good washing fastness; a noticeable reduction in the nanocomposite content was observed after 10 washing cycles, but no further significant loss occurred with additional washing. These findings suggest that the coating maintains reasonable durability under repeated laundering conditions [33,40]. Furthermore, enhancing the binding of ZnO and silica to the cotton matrix, potentially via chemical cross-linking or encapsulation methods, may reduce this risk and enhance safety for end users.
Finally, the use of OPBA as a silica source offers significant advantages in terms of cost-effectiveness and environmental sustainability. OPBA is an abundant agricultural waste product generated by palm oil-processing mills. Its use in this application not only reduces the reliance on more expensive and energy-intensive traditional silica precursors but also contributes to waste management and promotes a circular economy approach. The sustainability of our research is a key justification for exploring OPBA-based nanocomposites for functionalizing textiles.
4 Conclusion
In this study, a cotton fabric was successfully coated with a hybrid nanocomposite of OPBA and ZnO using a simple dip-pad–dry-cure method, which enhanced both the antibacterial activity and thermal properties. Antibacterial testing against S. aureus and E. coli revealed significant inhibition in the coated fabrics compared to the untreated controls. The OPBA:ZnO (1:1) coating demonstrated the strongest antibacterial effect against S. aureus, exhibiting a 3.9 mm inhibition zone. Although less pronounced, the ZnO-only coating still showed a 0.9 mm zone against S. aureus and a 2 mm zone against E. coli. ANOVA confirmed the statistical significance of these differences (p < 0.05), validating the effect of the coating. Thermal property analysis using DSC showed increased thermal stability of the coated fabrics, as evidenced by the increase in T g. The coated cotton fabric OPBA:ZnO (0:1) exhibited the highest T g increase, from 80.84°C in untreated cotton to 129.55°C in the coated fabric, indicating potential for improved performance in thermally demanding applications. SEM confirmed the successful deposition of the nanocomposite, revealing a change in the fiber surface texture. EDX detected elements in both OPBA (Si, Al, Ca, Mg, and Fe) and ZnO (Zn). XRD analysis indicated the presence of crystalline ZnO and alterations in the cellulose structure after coating. FTIR spectroscopy corroborated these findings and identified functional groups associated with cellulose, OPBA, and ZnO.
In terms of scalability, extensive silica extraction is feasible and cost-effective due to OPBA’s accessibility as an agricultural byproduct. Furthermore, the dip-pad–dry-cure coating method is widely accepted in the industry and can be incorporated into existing textile production lines. By using inexpensive and widely accessible reagents like acetic acid, NH4OH, and HCl, the process minimizes its negative effects on the environment while enabling economies of scale. Reproducibility may be affected by OPBA composition differences, where silica and impurity levels vary by source and processing. Frequent use, constant washing, and UV exposure may diminish the antibacterial efficacy unless the adhesion is enhanced further. Thorough safety and toxicity tests might be necessary for using wearable or medical textiles, especially when they involve exposure to ZnO NPs. To ensure reliable and safe performance at scale, further research is needed to address material variability, long-term durability, and regulatory requirements, even though commercial implementation seems promising. These enhanced antibacterial and thermal properties offer promising applications in healthcare, sportswear, and protective clothing.
Acknowledgments
We are grateful to the late Prof. Dr. Nurdin Bukit for his thoughtful feedback and guidance throughout this project. We also thank Badan Riset dan Inovasi Nasional for post-doctoral program that supported this study.
-
Funding information: The authors would like to thank “Riset Kolaborasi, Indonesia” for the research grant (contract number 23/UN5.4.10) K/PPM/KP-RKI/2024 and for providing the resources and supporting this study.
-
Author contributions: Erna Frida: conceptualized and designed the study. Ratnawulan: designed the study and critically reviewed the manuscript. Arif Hidayat: designed the study and critically reviewed the manuscript. Ahmad Taufiq: critically reviewed and revised the manuscript for important intellectual content. Bunga Fisikanta Bukit: performed data collection and analysis, contributed to the interpretation of the data, and drafted the initial manuscript. Firda Aulya Syamani: visualization and validation. Ferry Rahmat Astianta Bukit: visualization and validation. Istiqomah Rahmawati: investigation, visualization, and validation. Agus Wedi Pratama: writing – review and editing, visualization, and validation. All authors have accepted responsibility for the entire content of this manuscript and approved its submission.
-
Conflict of interest: The authors state no conflict of interest.
-
Data availability statement: All data generated or analyzed during this study are included in this published article.
References
[1] Mohamed, A. L., M. E. El-Naggar, and A. G. Hassabo. Preparation of hybrid nanoparticles to enhance the electrical conductivity and performance properties of cotton fabrics. Journal of Materials Research and Technology, Vol. 12, 2021, pp. 542–554.10.1016/j.jmrt.2021.02.035Search in Google Scholar
[2] Frida, E., N. Bukit, F. R. A. Bukit, and B. F. Bukit. Effect of hybrid filler oil palm boiler ash – bentonite on thermal characteristics of natural rubber compounds. Ecological Engineering and Environmental Technology, Vol. 24, 2023, pp. 205–213.10.12912/27197050/156961Search in Google Scholar
[3] Sharma, P., M. R. Hasan, N. K. Mehto, Deepak, A. Bishoyi, and J. Narang. 92 years of zinc oxide: has been studied by the scientific community since the 1930s- An overview. Sensors International, Vol. 3, 2022, id. 100182.10.1016/j.sintl.2022.100182Search in Google Scholar
[4] Fiedot-Toboła, M., M. Ciesielska, I. Maliszewska, O. Rac-Rumijowska, P. Suchorska-Woźniak, H. Teterycz, et al. Deposition of zinc oxide on different polymer textiles and their antibacterial properties. Materials, Vol. 11, 2018, pp. 1–16.10.3390/ma11050707Search in Google Scholar PubMed PubMed Central
[5] Barani, H. Preparation of antibacterial coating based on in situ synthesis of ZnO/SiO2 hybrid nanocomposite on cotton fabric. Applied Surface Science, Vol. 320, 2014, pp. 429–434.10.1016/j.apsusc.2014.09.102Search in Google Scholar
[6] Küçük, M. and M. L. Öveçoğlu. Fabrication of SiO2–ZnO NP/ZnO NR hybrid coated cotton fabrics: the effect of ZnO NR growth time on structural and UV protection characteristics. Cellulose, Vol. 2, 2020, pp. 1773–1793.10.1007/s10570-019-02891-2Search in Google Scholar
[7] Ginting, E. M., N. Bukit, E. Frida, and B. F. Bukit. Microstructure and thermal properties of natural rubber compound with palm oil boilers ash for nanoparticle filler. Case Studies in Thermal Engineering, Vol. 17, 2020, id. 100575.10.1016/j.csite.2019.100575Search in Google Scholar
[8] Frida, E., F. Rahmat, A. Bukit, and F. Bukit. Analysis structure and morphology of bentonite-opba. Journal of Applied Research and Technology, Vol. 20, 2022, pp. 117–125.10.22201/icat.24486736e.2022.20.2.1710Search in Google Scholar
[9] Bukit, N., E. M. Ginting, E. A. Hutagalung, E. Sidebang, E. Frida, and B. F. Bukit. Preparation and characterization of oil palm ash from boiler to nanoparticle. Reviews on Advanced Materials Science, Vol. 58, 2019, pp. 195–200.10.1515/rams-2019-0023Search in Google Scholar
[10] Bukit, B. F., A. W. Pratama, E. Frida, B. B. Sedayu, D. Fransiska, D. Purnomo, et al. Eco-friendly alginate/PCL-TiO2 hybrid biocomposites: Preparation, properties, and methylene blue photodegradation. South African Journal of Chemical Engineering, Vol. 51, 2025, pp. 254–264.10.1016/j.sajce.2024.12.003Search in Google Scholar
[11] Lu, H. F., B. Fei, J. H. Xin, R. Wang, and L. Li. Fabrication of UV-blocking nanohybrid coating via miniemulsion polymerization. Journal of Colloid and Interface Science, Vol. 300, 2006, pp. 111–116.10.1016/j.jcis.2006.03.059Search in Google Scholar PubMed
[12] Ökte, A. N. and D. Karamanis. A novel photoresponsive ZnO-flyash nanocomposite for environmental and energy applications. Applied Catalysis, B: Environmental, Vol. 142–143, 2013, pp. 538–552.10.1016/j.apcatb.2013.05.045Search in Google Scholar
[13] Nozari, B., M. Montazer, and M. Mahmoudi Rad. Stable ZnO/SiO2 nano coating on polyester for anti-bacterial, self-cleaning and flame retardant applications. Materials Chemistry and Physics, Vol. 267, 2021, id. 124674.10.1016/j.matchemphys.2021.124674Search in Google Scholar
[14] Pompe, C. E., M. Slagter, P. E. de Jongh, and K. P. de Jong. Impact of heterogeneities in silica-supported copper catalysts on their stability for methanol synthesis. Journal of Catalysis, Vol. 365, 2018, pp. 1–9.10.1016/j.jcat.2018.06.014Search in Google Scholar
[15] Khatun, M. and T. Rahman. Development of pad-dry curing method with zero discharge for 2022. International Journal of Sustainable Agricultural Technology, Vol. 17. 2021, pp. 1–05.Search in Google Scholar
[16] Ferreira, D. P., A. Ferreira, and R. Fangueiro. Searching for natural conductive fibrous structures via a green sustainable approach based on jute fibers and silver nanoparticles. Polymers (Basel), Vol. 10, 2018, id. 10.10.3390/polym10010063Search in Google Scholar PubMed PubMed Central
[17] Frida, E., Ratnawulan, N. Bukit, B. F. Bukit, A. Taufiq, A. W. Pratama, et al. Superhydrophilic and self-cleaning properties of cotton fabric coated with oil palm boiler ash and titanium dioxide. Case Studies in Chemical and Environmental Engineering, Vol. 10, 2024, id. 100946.10.1016/j.cscee.2024.100946Search in Google Scholar
[18] Handore, K., S. Bhavsar, A. Horne, P. Chhattise, K. Mohite, J. Ambekar, et al. Novel green route of synthesis of ZnO nanoparticles by using natural biodegradable polymer and its application as a catalyst for oxidation of aldehydes. Journal of Macromolecular Science, Part A: Pure and Applied Chemistry, Vol. 51, 2014, pp. 941–947.10.1080/10601325.2014.967078Search in Google Scholar
[19] Bukit, N., E. M. Ginting, E. Frida, and B. F. Bukit. Preparation of environmentally friendly adsorbent using oil palm boiler ash. Bentonite and Titanium Dioxide Nanocomposite Materials, Vol. 23, 2022, pp. 75–82.10.12911/22998993/155020Search in Google Scholar
[20] Supramaniam, J., D. Y. S. Low, S. K. Wong, L. T. H. Tan, B. F. Leo, B. H. Goh, et al. Facile synthesis and characterization of palm CNF-ZnO nanocomposites with antibacterial and reinforcing properties. International Journal of Molecular Sciences, Vol. 22, 2021, pp. 1–15.10.3390/ijms22115781Search in Google Scholar PubMed PubMed Central
[21] Hosseinali, F. and J. A. Thomasson. Multiscale frictional properties of cotton fibers: A review. Fibers, Vol. 6, 2018, pp. 1–29.10.3390/fib6030049Search in Google Scholar
[22] Cabral, A. T., A. R. G. O. Junior, G. Y. Koga, I. C. Rigoli, C. L. F. Rocha, and C. A. C. Souza. Electrodeposited zinc cellulose nanocrystals composite coatings: Morphology, structure, corrosion resistance and electrodeposition process. Journal of Materials Research and Technology, Vol. 33, 2024, pp. 1569–1580.10.1016/j.jmrt.2024.09.153Search in Google Scholar
[23] Boticas, I., D. Dias, D. Ferreira, P. Magalhães, R. Silva, and R. Fangueiro. Superhydrophobic cotton fabrics based on ZnO nanoparticles functionalization. SN Appl Sci, Vol. 1, 2019, pp. 1–9.10.1007/s42452-019-1423-2Search in Google Scholar
[24] Bukit, B. F., E. Frida, S. Humaidi, P. Sinuhaji, and N. Bukit. Optimization of palm oil boiler ash biomass waste as a source of silica with various preparation methods. Vol. 23, 2022, pp. 193–199.10.12911/22998993/150694Search in Google Scholar
[25] Nozari, B., M. Montazer, and M. M. Rad. In-situ Synthesis of SiO 2 Nanoparticles on Polyester Fabric as Benign Multi-purpose Catalysts. Fibers and Polymers, Vol. 19, 2018, pp. 2564–2573.10.1007/s12221-018-8668-zSearch in Google Scholar
[26] Gong, J., J. Li, J. Xu, Z. Xiang, and L. Mo. Research on cellulose nanocrystals produced from cellulose sources with various polymorphs. RSC Advances, Vol. 7, 2017, pp. 33486–33493.10.1039/C7RA06222BSearch in Google Scholar
[27] Kathirvelu, S., L. D’Souza, and B. Dhurai. protection finishing of textiles using ZnO nanoparticles. Indian Journal of Fibre and Textile Research, Vol. 34, 2009, pp. 267–273.Search in Google Scholar
[28] Willhammar, T., K. Daicho, D. N. Johnstone, K. Kobayashi, Y. Liu, P. A. Midgley, et al. Local crystallinity in twisted cellulose nanofibers. ACS Nano, Vol. 15, 2021, pp. 2730–2737.10.1021/acsnano.0c08295Search in Google Scholar PubMed PubMed Central
[29] Arafati, A., E. Borhani, S. M. S. Nourbakhsh, and H. Abdoos. Synthesis and characterization of tetragonal/monoclinic mixed phases nanozirconia powders. Ceramics International, Vol. 45, 2019, pp. 12975–12982.10.1016/j.ceramint.2019.03.225Search in Google Scholar
[30] Yazdanshenas, M. E. and M. Shateri-Khalilabad. In situ synthesis of silver nanoparticles on alkali-treated cotton fabrics. Journal of Industrial Textiles, Vol. 42, 2013, pp. 459–474.10.1177/1528083712444297Search in Google Scholar
[31] Kahouli, M., A. Barhoumi, A. Bouzid, A. Al-Hajry, and S. Guermazi. Structural and optical properties of ZnO nanoparticles prepared by direct precipitation method. Superlattices and Microstructures, Vol. 85, 2015, pp. 7–23.10.1016/j.spmi.2015.05.007Search in Google Scholar
[32] Abdullah, M. M., M. M. Rahman, H. Bouzid, M. Faisal, S. B. Khan, S. A. Al-Sayari, et al. Sensitive and fast response ethanol chemical sensor based on as-grown Gd2O3 nanostructures. Journal of Rare Earths, Vol. 33, 2015, pp. 214–220.10.1016/S1002-0721(14)60405-1Search in Google Scholar
[33] Bukit, B. F., E. Frida, S. Humaidi, and P. Sinuhaji. Selfcleaning and antibacterial activities of textiles using nanocomposite oil palm boiler ash (OPBA), TiO2 and chitosan as coating. South African Journal of Chemical Engineering, Vol. 41, 2022, pp. 105–110.10.1016/j.sajce.2022.05.007Search in Google Scholar
[34] Radetić, M. Functionalization of textile materials with TiO2 nanoparticles. Journal of Photochemistry and Photobiology, C: Photochemistry Reviews, Vol. 16, 2013, pp. 62–76.10.1016/j.jphotochemrev.2013.04.002Search in Google Scholar
[35] Ibrahim, N. A., B. M. Eid, E. A. El-Aziz, T. M. Abou Elmaaty, and S. M. Ramadan. Multifunctional cellulose-containing fabrics using modified finishing formulations. RSC Advances, Vol. 7, 2017, pp. 33219–33230.10.1039/C7RA05403CSearch in Google Scholar
[36] Sirelkhatim, A., S. Mahmud, A. Seeni, N. H. M. Kaus, L. C. Ann, S. K. M. Bakhori, et al. Review on zinc oxide nanoparticles: Antibacterial activity and toxicity mechanism. Nano-Micro Letters, Vol. 7, 2015, pp. 219–242.10.1007/s40820-015-0040-xSearch in Google Scholar PubMed PubMed Central
[37] Franco, D., G. Calabrese, S. P. P. Guglielmino, and S. Conoci. Metal-based nanoparticles: antibacterial mechanisms and biomedical application. Microorganisms, Vol. 10, 2022, id. 1778.10.3390/microorganisms10091778Search in Google Scholar PubMed PubMed Central
[38] Yang, D., C. Chen, Z. Zheng, H. Liu, E. R. Waclawik, Z. Yan, et al. Grafting silica species on anatase surface for visible light photocatalytic activity. Energy & Environmental Science, Vol. 4, 2011, pp. 2279–2287.10.1039/c1ee01182kSearch in Google Scholar
[39] Navidpour, A. H., S. Abbasi, D. Li, A. Mojiri, and J. L. Zhou. Investigation of advanced oxidation process in the presence of TiO2 semiconductor as photocatalyst: property, principle, kinetic analysis, and photocatalytic activity. Catalysts, Vol. 13, 2023, pp. 1–29.10.3390/catal13020232Search in Google Scholar
[40] Bukit, B. F. and S. H. Sirait. Preparasi dispersi antibakteri berbahan dasar titanium dioksida (Tio2) serta aplikasinya pada kain dengan metoda dip coating. JUITECH (Jurnal Ilmiah Fakultas Teknik Universitas Quality), Vol. 3, 2019, pp. 640–644.10.36764/ju.v3i2.259Search in Google Scholar
© 2025 the author(s), published by De Gruyter
This work is licensed under the Creative Commons Attribution 4.0 International License.
Articles in the same Issue
- Review Articles
- Utilization of steel slag in concrete: A review on durability and microstructure analysis
- Technical development of modified emulsion asphalt: A review on the preparation, performance, and applications
- Recent developments in ultrasonic welding of similar and dissimilar joints of carbon fiber reinforcement thermoplastics with and without interlayer: A state-of-the-art review
- Unveiling the crucial factors and coating mitigation of solid particle erosion in steam turbine blade failures: A review
- From magnesium oxide, magnesium oxide concrete to magnesium oxide concrete dams
- Properties and potential applications of polymer composites containing secondary fillers
- A scientometric review on the utilization of copper slag as a substitute constituent of ordinary Portland cement concrete
- Advancement of additive manufacturing technology in the development of personalized in vivo and in vitro prosthetic implants
- Recent advance of MOFs in Fenton-like reaction
- A review of defect formation, detection, and effect on mechanical properties of three-dimensional braided composites
- Non-conventional approaches to producing biochars for environmental and energy applications
- Review of the development and application of aluminum alloys in the nuclear industry
- Advances in the development and characterization of combustible cartridge cases and propellants: Preparation, performance, and future prospects
- Recent trends in rubberized and non-rubberized ultra-high performance geopolymer concrete for sustainable construction: A review
- Cement-based materials for radiative cooling: Potential, material and structural design, and future prospects
- A comprehensive review: The impact of recycling polypropylene fiber on lightweight concrete performance
- A comprehensive review of preheating temperature effects on reclaimed asphalt pavement in the hot center plant recycling
- Exploring the potential applications of semi-flexible pavement: A comprehensive review
- A critical review of alkali-activated metakaolin/blast furnace slag-based cementitious materials: Reaction evolution and mechanism
- Dispersibility of graphene-family materials and their impact on the properties of cement-based materials: Application challenges and prospects
- Research Articles
- Investigation of the corrosion performance of HVOF-sprayed WC-CoCr coatings applied on offshore hydraulic equipment
- A systematic review of metakaolin-based alkali-activated and geopolymer concrete: A step toward green concrete
- Evaluation of color matching of three single-shade composites employing simulated 3D printed cavities with different thicknesses using CIELAB and CIEDE2000 color difference formulae
- Novel approaches in prediction of tensile strain capacity of engineered cementitious composites using interpretable approaches
- Effect of TiB2 particles on the compressive, hardness, and water absorption responses of Kulkual fiber-reinforced epoxy composites
- Analyzing the compressive strength, eco-strength, and cost–strength ratio of agro-waste-derived concrete using advanced machine learning methods
- Tensile behavior evaluation of two-stage concrete using an innovative model optimization approach
- Tailoring the mechanical and degradation properties of 3DP PLA/PCL scaffolds for biomedical applications
- Optimizing compressive strength prediction in glass powder-modified concrete: A comprehensive study on silicon dioxide and calcium oxide influence across varied sample dimensions and strength ranges
- Experimental study on solid particle erosion of protective aircraft coatings at different impact angles
- Compatibility between polyurea resin modifier and asphalt binder based on segregation and rheological parameters
- Fe-containing nominal wollastonite (CaSiO3)–Na2O glass-ceramic: Characterization and biocompatibility
- Relevance of pore network connectivity in tannin-derived carbons for rapid detection of BTEX traces in indoor air
- A life cycle and environmental impact analysis of sustainable concrete incorporating date palm ash and eggshell powder as supplementary cementitious materials
- Eco-friendly utilisation of agricultural waste: Assessing mixture performance and physical properties of asphalt modified with peanut husk ash using response surface methodology
- Benefits and limitations of N2 addition with Ar as shielding gas on microstructure change and their effect on hardness and corrosion resistance of duplex stainless steel weldments
- Effect of selective laser sintering processing parameters on the mechanical properties of peanut shell powder/polyether sulfone composite
- Impact and mechanism of improving the UV aging resistance performance of modified asphalt binder
- AI-based prediction for the strength, cost, and sustainability of eggshell and date palm ash-blended concrete
- Investigating the sulfonated ZnO–PVA membrane for improved MFC performance
- Strontium coupling with sulphur in mouse bone apatites
- Transforming waste into value: Advancing sustainable construction materials with treated plastic waste and foundry sand in lightweight foamed concrete for a greener future
- Evaluating the use of recycled sawdust in porous foam mortar for improved performance
- Improvement and predictive modeling of the mechanical performance of waste fire clay blended concrete
- Polyvinyl alcohol/alginate/gelatin hydrogel-based CaSiO3 designed for accelerating wound healing
- Research on assembly stress and deformation of thin-walled composite material power cabin fairings
- Effect of volcanic pumice powder on the properties of fiber-reinforced cement mortars in aggressive environments
- Analyzing the compressive performance of lightweight foamcrete and parameter interdependencies using machine intelligence strategies
- Selected materials techniques for evaluation of attributes of sourdough bread with Kombucha SCOBY
- Establishing strength prediction models for low-carbon rubberized cementitious mortar using advanced AI tools
- Investigating the strength performance of 3D printed fiber-reinforced concrete using applicable predictive models
- An eco-friendly synthesis of ZnO nanoparticles with jamun seed extract and their multi-applications
- The application of convolutional neural networks, LF-NMR, and texture for microparticle analysis in assessing the quality of fruit powders: Case study – blackcurrant powders
- Study of feasibility of using copper mining tailings in mortar production
- Shear and flexural performance of reinforced concrete beams with recycled concrete aggregates
- Advancing GGBS geopolymer concrete with nano-alumina: A study on strength and durability in aggressive environments
- Leveraging waste-based additives and machine learning for sustainable mortar development in construction
- Study on the modification effects and mechanisms of organic–inorganic composite anti-aging agents on asphalt across multiple scales
- Morphological and microstructural analysis of sustainable concrete with crumb rubber and SCMs
- Structural, physical, and luminescence properties of sodium–aluminum–zinc borophosphate glass embedded with Nd3+ ions for optical applications
- Eco-friendly waste plastic-based mortar incorporating industrial waste powders: Interpretable models for flexural strength
- Bioactive potential of marine Aspergillus niger AMG31: Metabolite profiling and green synthesis of copper/zinc oxide nanocomposites – An insight into biomedical applications
- Preparation of geopolymer cementitious materials by combining industrial waste and municipal dewatering sludge: Stabilization, microscopic analysis and water seepage
- Seismic behavior and shear capacity calculation of a new type of self-centering steel-concrete composite joint
- Sustainable utilization of aluminum waste in geopolymer concrete: Influence of alkaline activation on microstructure and mechanical properties
- Optimization of oil palm boiler ash waste and zinc oxide as antibacterial fabric coating
- Special Issue on Recent Advancement in Low-carbon Cement-based Materials - Part II
- Investigating the effect of locally available volcanic ash on mechanical and microstructure properties of concrete
- Flexural performance evaluation using computational tools for plastic-derived mortar modified with blends of industrial waste powders
- Foamed geopolymers as low carbon materials for fire-resistant and lightweight applications in construction: A review
- Autogenous shrinkage of cementitious composites incorporating red mud
- Special Issue on AI-Driven Advances for Nano-Enhanced Sustainable Construction Materials
- Advanced explainable models for strength evaluation of self-compacting concrete modified with supplementary glass and marble powders
- Special Issue on Advanced Materials for Energy Storage and Conversion
- Innovative optimization of seashell ash-based lightweight foamed concrete: Enhancing physicomechanical properties through ANN-GA hybrid approach
Articles in the same Issue
- Review Articles
- Utilization of steel slag in concrete: A review on durability and microstructure analysis
- Technical development of modified emulsion asphalt: A review on the preparation, performance, and applications
- Recent developments in ultrasonic welding of similar and dissimilar joints of carbon fiber reinforcement thermoplastics with and without interlayer: A state-of-the-art review
- Unveiling the crucial factors and coating mitigation of solid particle erosion in steam turbine blade failures: A review
- From magnesium oxide, magnesium oxide concrete to magnesium oxide concrete dams
- Properties and potential applications of polymer composites containing secondary fillers
- A scientometric review on the utilization of copper slag as a substitute constituent of ordinary Portland cement concrete
- Advancement of additive manufacturing technology in the development of personalized in vivo and in vitro prosthetic implants
- Recent advance of MOFs in Fenton-like reaction
- A review of defect formation, detection, and effect on mechanical properties of three-dimensional braided composites
- Non-conventional approaches to producing biochars for environmental and energy applications
- Review of the development and application of aluminum alloys in the nuclear industry
- Advances in the development and characterization of combustible cartridge cases and propellants: Preparation, performance, and future prospects
- Recent trends in rubberized and non-rubberized ultra-high performance geopolymer concrete for sustainable construction: A review
- Cement-based materials for radiative cooling: Potential, material and structural design, and future prospects
- A comprehensive review: The impact of recycling polypropylene fiber on lightweight concrete performance
- A comprehensive review of preheating temperature effects on reclaimed asphalt pavement in the hot center plant recycling
- Exploring the potential applications of semi-flexible pavement: A comprehensive review
- A critical review of alkali-activated metakaolin/blast furnace slag-based cementitious materials: Reaction evolution and mechanism
- Dispersibility of graphene-family materials and their impact on the properties of cement-based materials: Application challenges and prospects
- Research Articles
- Investigation of the corrosion performance of HVOF-sprayed WC-CoCr coatings applied on offshore hydraulic equipment
- A systematic review of metakaolin-based alkali-activated and geopolymer concrete: A step toward green concrete
- Evaluation of color matching of three single-shade composites employing simulated 3D printed cavities with different thicknesses using CIELAB and CIEDE2000 color difference formulae
- Novel approaches in prediction of tensile strain capacity of engineered cementitious composites using interpretable approaches
- Effect of TiB2 particles on the compressive, hardness, and water absorption responses of Kulkual fiber-reinforced epoxy composites
- Analyzing the compressive strength, eco-strength, and cost–strength ratio of agro-waste-derived concrete using advanced machine learning methods
- Tensile behavior evaluation of two-stage concrete using an innovative model optimization approach
- Tailoring the mechanical and degradation properties of 3DP PLA/PCL scaffolds for biomedical applications
- Optimizing compressive strength prediction in glass powder-modified concrete: A comprehensive study on silicon dioxide and calcium oxide influence across varied sample dimensions and strength ranges
- Experimental study on solid particle erosion of protective aircraft coatings at different impact angles
- Compatibility between polyurea resin modifier and asphalt binder based on segregation and rheological parameters
- Fe-containing nominal wollastonite (CaSiO3)–Na2O glass-ceramic: Characterization and biocompatibility
- Relevance of pore network connectivity in tannin-derived carbons for rapid detection of BTEX traces in indoor air
- A life cycle and environmental impact analysis of sustainable concrete incorporating date palm ash and eggshell powder as supplementary cementitious materials
- Eco-friendly utilisation of agricultural waste: Assessing mixture performance and physical properties of asphalt modified with peanut husk ash using response surface methodology
- Benefits and limitations of N2 addition with Ar as shielding gas on microstructure change and their effect on hardness and corrosion resistance of duplex stainless steel weldments
- Effect of selective laser sintering processing parameters on the mechanical properties of peanut shell powder/polyether sulfone composite
- Impact and mechanism of improving the UV aging resistance performance of modified asphalt binder
- AI-based prediction for the strength, cost, and sustainability of eggshell and date palm ash-blended concrete
- Investigating the sulfonated ZnO–PVA membrane for improved MFC performance
- Strontium coupling with sulphur in mouse bone apatites
- Transforming waste into value: Advancing sustainable construction materials with treated plastic waste and foundry sand in lightweight foamed concrete for a greener future
- Evaluating the use of recycled sawdust in porous foam mortar for improved performance
- Improvement and predictive modeling of the mechanical performance of waste fire clay blended concrete
- Polyvinyl alcohol/alginate/gelatin hydrogel-based CaSiO3 designed for accelerating wound healing
- Research on assembly stress and deformation of thin-walled composite material power cabin fairings
- Effect of volcanic pumice powder on the properties of fiber-reinforced cement mortars in aggressive environments
- Analyzing the compressive performance of lightweight foamcrete and parameter interdependencies using machine intelligence strategies
- Selected materials techniques for evaluation of attributes of sourdough bread with Kombucha SCOBY
- Establishing strength prediction models for low-carbon rubberized cementitious mortar using advanced AI tools
- Investigating the strength performance of 3D printed fiber-reinforced concrete using applicable predictive models
- An eco-friendly synthesis of ZnO nanoparticles with jamun seed extract and their multi-applications
- The application of convolutional neural networks, LF-NMR, and texture for microparticle analysis in assessing the quality of fruit powders: Case study – blackcurrant powders
- Study of feasibility of using copper mining tailings in mortar production
- Shear and flexural performance of reinforced concrete beams with recycled concrete aggregates
- Advancing GGBS geopolymer concrete with nano-alumina: A study on strength and durability in aggressive environments
- Leveraging waste-based additives and machine learning for sustainable mortar development in construction
- Study on the modification effects and mechanisms of organic–inorganic composite anti-aging agents on asphalt across multiple scales
- Morphological and microstructural analysis of sustainable concrete with crumb rubber and SCMs
- Structural, physical, and luminescence properties of sodium–aluminum–zinc borophosphate glass embedded with Nd3+ ions for optical applications
- Eco-friendly waste plastic-based mortar incorporating industrial waste powders: Interpretable models for flexural strength
- Bioactive potential of marine Aspergillus niger AMG31: Metabolite profiling and green synthesis of copper/zinc oxide nanocomposites – An insight into biomedical applications
- Preparation of geopolymer cementitious materials by combining industrial waste and municipal dewatering sludge: Stabilization, microscopic analysis and water seepage
- Seismic behavior and shear capacity calculation of a new type of self-centering steel-concrete composite joint
- Sustainable utilization of aluminum waste in geopolymer concrete: Influence of alkaline activation on microstructure and mechanical properties
- Optimization of oil palm boiler ash waste and zinc oxide as antibacterial fabric coating
- Special Issue on Recent Advancement in Low-carbon Cement-based Materials - Part II
- Investigating the effect of locally available volcanic ash on mechanical and microstructure properties of concrete
- Flexural performance evaluation using computational tools for plastic-derived mortar modified with blends of industrial waste powders
- Foamed geopolymers as low carbon materials for fire-resistant and lightweight applications in construction: A review
- Autogenous shrinkage of cementitious composites incorporating red mud
- Special Issue on AI-Driven Advances for Nano-Enhanced Sustainable Construction Materials
- Advanced explainable models for strength evaluation of self-compacting concrete modified with supplementary glass and marble powders
- Special Issue on Advanced Materials for Energy Storage and Conversion
- Innovative optimization of seashell ash-based lightweight foamed concrete: Enhancing physicomechanical properties through ANN-GA hybrid approach